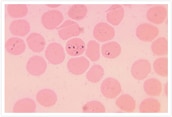

複数種のマラリア原虫を病原体とし、ハマダラカに媒介されて感染する病気です。4000年以上前から知られている病気で、「マラリア」という名称は、イタリア語の「悪い空気(mal’aria)」に由来しているとも言われています。
2014年にWHO(世界保健機関)が報告したレポートによれば、世界で32億人もの人に感染リスクがあると推定されています。無症状から発熱、死に至る重いものまで症状は様々ですが、熱帯熱マラリアで合併症がある場合には致死率が高いため、直ちに治療が必要です。
感染原因
マラリアは、病原体であるマラリア原虫を持つハマダラカに媒介されて人に感染する寄生虫症です。人体に感染する原虫には4種類(熱帯熱マラリア原虫、三日熱マラリア原虫、四日熱マラリア原虫、卵型マラリア原虫)あり、熱帯熱と三日熱がもっとも一般的です。近年、第5のヒト・マラリアと言われるサル・マラリア原虫も東南アジアの各地で報告されています。
吸血時に原虫(スポロゾイト)が体内に注入されると、原虫はまず肝細胞の中で増殖し、血液中に移行して、次に赤血球の中で増殖します。その後、赤血球を破壊して次の赤血球に浸入、また増殖して破壊する、というサイクルを繰り返します。マラリアの基本症状は、赤血球が破壊される時に現れますが、原虫による増殖および破壊のサイクルの違いが、三日熱、四日熱の名前の由来になっています。
病原体:マラリア原虫
媒介昆虫:ハマダラカ


参照情報:
U.S. Centers for Disease Control and Prevention, "Malaria" Accessed March 19, 2014,
http://www.cdc.gov/dpdx/malaria/
症状
マラリアの症状は、マラリア原虫が赤血球内で増殖する際に代謝産物として生成する有毒な物質が、赤血球の破壊時に血液中に放出されることで引き起こされます。
症状は、無症状から死に至る重いものまで様々で、原虫の種類や合併症の有無により症状が異なりますが、いずれの場合でも7~30日は無症状期があります。三日熱マラリア原虫や卵型マラリア原虫に感染した場合には、初期症状が治まって数カ月〜数年後に、再発することがあります。この再発は、熱帯熱などの症状再発現(再燃)とはメカニズムが異なっており、注意が必要です。
マラリアの感染原因(原虫)別の症状
熱帯熱マラリア
毎日(1日に複数回の場合もあり)発熱します。発熱は不規則なことが多く、診断基準としては有用ではありません。熱帯熱マラリアの特徴は多様な合併症があることで、このようなマラリアを重症マラリア(severe and complicated malaria)と呼びます。このような合併症には、「異常行動、意識障害、発作、こん睡や神経障害といった症状を伴う脳マラリア」、「赤血球の破壊による深刻な貧血」、「急性呼吸逼迫症候群(ARDS)」、「血液凝固の異常」、「心臓血管系の不全による低血圧」などがあげられ、合併しておこることもあります。熱帯熱の死亡原因としてもっとも重要なものです。
三日熱マラリア
48時間ごとに発熱を繰り返します。
もっとも顕著に見られる症状は、発熱、悪寒、発汗、頭痛、悪心と嘔吐、体の痛み、全身倦怠感です。
卵型マラリア
48~50時間ごとに発熱を繰り返します。
症状は「三日熱マラリア」と同じです。
四日熱マラリア
72時間ごとに発熱を繰り返します。
治療方法
マラリアは重症化することもありますが、迅速に適切な処置をすれば治癒できます。
診断方法
ギムザ染色を施して薄層塗沫標本とした血液中にマラリア原虫がいるかどうかを光学顕微鏡で確認し、原虫がいる場合はその種類を特定します。さらに詳細な診断として、いわゆるディップスティックなどの方法があります。また、貧血、血小板減少、ビリルビン増加、アミノトランスフェラーゼ増加の有無の確認などが必要になります。
治療方法
マラリアは原虫の種類により症状の重さが異なります。三日熱マラリア、卵型マラリア、四日熱マラリアは比較的軽症ですが、熱帯熱マラリアは合併症を伴って重症化しやすく、死に至るケースもあります。
三日熱マラリア、卵型マラリア、四日熱マラリアでは、クロロキン、プリマキンといった薬剤を使用します。熱帯熱マラリアの場合には、合併症がない場合とある場合で治療法は異なります。
熱帯熱マラリアで合併症がない場合
アルテミシニン系をベースとした併用療法(ACT)がもっとも効果的です。
合併症がある場合(重症熱帯熱マラリア)
治療をしなければ高い確率で死に至るため、直ちに治療が必要で、薬剤の血中濃度を速やかに有効濃度に上昇させることが重要です。アルテミシニン系をベースとした併用療法と補助療法、そしてこれらに続く輸液などの支持療法が必要です。
予防方法
殺虫剤入りの蚊帳や殺虫剤を使用して、ハマダラカを駆除することが最大の予防法です。あるいはDEETという蚊の忌避剤を塗布・スプレーすることも行われます。人への安全性が高く、防虫効果が長持ちする殺虫剤練りこみ蚊帳として、住友化学の開発した「オリセット® ネット」があります。
抗マラリア薬も予防に一定の効果があります。WHO(世界保健機関)では感染リスクの高い地域に住む妊娠初期以降の妊婦に対して、スルファドキシン−ピリメタリンを一定の期間ごとに投薬することを推奨しています。同様にこれらの危険地域の子供に対しても、同じ薬剤を3回断続的に投薬することを推奨しています。
感染リスクのある地域
マラリアは、高温多湿・雨が多い地域で多く見られます。もっともリスクが高い地域はサハラ以南のアフリカです。加えて、東南アジア、ラテンアメリカ、中東、合わせて世界91の国や地域でマラリアの感染が確認されています。先進国における輸入マラリアにも留意する必要があります。

推定感染者数
2015年には、約2.1億人が感染したと推定されています。マラリアに対する免疫のない子供や免疫が低下している妊婦が感染しやすい傾向にあります。
推定死亡者数
2015年に約44万人がマラリアによって死亡したと推定されます。そのうちの90%はアフリカからの報告です。
参照情報:
WHO- Malaria, accessed February 16, 2017
http://www.who.int/topics/malaria/en/
CDC- Malaria, accessed February 16, 2017
http://www.cdc.gov/malaria/